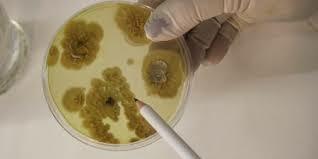
Niveles patología

-
Padre anatomía patológica,15 a 20 autopsias
-
Criterio mas orgánico dividendo la medicina en fisiología, patología y terapéutica. Divide las enfermedades en grupos generales especiales.
-
Descripción de endocarditis, cirrosis. Error atribuir a la lesión morfológica de la casualidad.
-
Crea la noción del tejido al someter los órganos a desecación, cocción y adición de ácidos.
-
Realizo 300 autopsias, descubrió la diferencia entre neumonía lobar y lobulillar. Degeneración amiloide del riñón.
-
Enuncio el principio básico de la biología
Las células son las unidades de vida.
Los tejidos y las órganos están compuestos por células.
Las células son nutridas por vasos sanguíneos -
Estudios microscópicos
-
Teoría neuronal
Estructura del sistema nervioso, demostró que las prolongaciones nerviosas estaban continuas, -
Garrod: error congénito del metabolismo.
Beadle: gen= encima = reacción.
Peters: lesión bioquímica.
Pauling: enfermedad molecular. -
Estudios macroscópicos
Looking for a timeline maker?
Create timelines for projects, roadmaps, history, lessons, legal cases, and stories with Timetoast. Timetoast is a timeline maker for work, school, research, and stories.